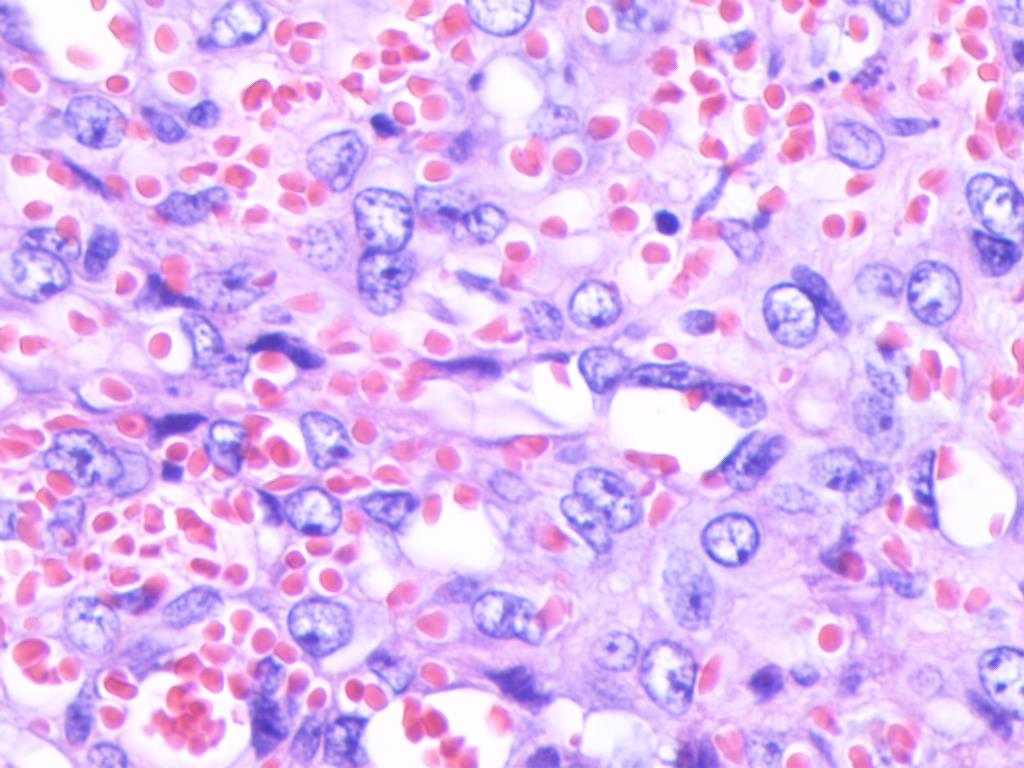
20250412_nc9z4

病例介绍:颌下腺的罕见肿物
一位51岁的男性患者,因无意中发现左侧面部出现一“核桃”大小的肿物而就诊。该肿物伴有轻微自发性疼痛,但无明显触痛或麻木感。初步检查指向颌下腺区域的异常。
影像学与大体检查发现
面部CT平扫显示,左侧颌下区域存在一团块状软组织密度影,尺寸约为3.8cm×3.0cm×2.8cm。增强扫描揭示肿块呈不均匀强化,内部可见斑片状强化区域及血管影像。病灶与邻近的左侧颌下腺及咬肌界限不清,周围脂肪密度略有增高,并伴有增大的淋巴结影。
随后,患者接受了局部麻醉下的颌下腺肿物切除术。
大体检查:
切除的组织标本不规则,大小为5.2cm×4.3cm×3.0cm。其中包含一个直径约4.0cm的结节状肿物,质地软嫩,看似有厚包膜。切面呈灰红色,可见出血与坏死区域。
关键病理发现:复合性血管内皮瘤的镜下特征
显微镜下观察(图1A)显示,肿瘤富含血管,并呈浸润性生长模式。复合性血管内皮瘤(Composite Hemangioendothelioma, CHE)的诊断特点在于其混合了不同类型的血管肿瘤成分,本病例中主要包括:
1. 良性血管瘤成分 (占比较大):
- 海绵状血管瘤 (约40%): 镜下可见扩张的薄壁血管构成的管腔,大小不一,腔内充满血液。
- 梭形细胞血管瘤 (约15%): 主要由显著的梭形细胞组成,呈束状、片状排列,细胞核相对一致,无明显异型性。
- 毛细血管瘤 (约5%): 由增生扩张的毛细血管构成,呈分叶状、结节状分布,血管腔细小或缺如,内皮细胞扁平,可见核分裂象但无病理性核分裂。
2. 中间型血管瘤成分:
- 网状血管内皮瘤 (约15%): 特征为细长分支状血管相互吻合形成网状结构,类似睾丸网。管腔内衬覆“靴钉样”内皮细胞,细胞核圆、深染。
- 血管内乳头状血管内皮瘤 (约10%): 内皮细胞呈乳头状或肾小球样增生,乳头中央有玻璃样间质轴心,表面衬覆“鞋钉样”内皮细胞。
3. 恶性血管瘤成分:
- 上皮样血管内皮瘤 (约10%; 图1B): 由分支状肿瘤性血管构成,可见梭形或上皮样嗜酸性内皮细胞呈索状、巢状排列,形成原始血管腔样结构,腔内含红细胞。细胞周围可见黏液玻璃样间质,细胞核有中度异型性,分裂象活跃。
- 高分化血管肉瘤 (约5%; 图1C): 肿瘤细胞弥漫分布于血管周围间质,多形性和异型性不显著,局灶可见坏死、核分裂象和巨核细胞。
病理组织学图像(HE染色):

图1A:肿瘤位于颌下腺内,富含血管呈浸润性生长,伴出血坏死 (×100)
图1B:上皮样血管内皮瘤区域,细胞椭圆形、胞浆丰富,核仁明显 (×200)

图1C:高分化血管肉瘤区域,肿瘤细胞轻度异型,可见病理性核分裂 (×200)
免疫组化分析
免疫组织化学染色结果进一步支持了诊断:
- 血管内皮标记物 ERG (图2A)、FLI-1、CD31、CD34、F8 在各种良性、中间性和恶性血管肿瘤成分的瘤细胞中均呈阳性表达。
- 平滑肌肌动蛋白 (SMA)、上皮膜抗原 (EMA)、CAMTA1、细胞角蛋白 (CK8/18)、淋巴管内皮标记物 D2-40 (图2B) 在所有肿瘤成分中均不表达。
- 增殖指数 Ki-67 阳性率在不同区域约为1%至15% (图2C),提示存在一定的增殖活性。
免疫组化结果图像(× 100):

图2A:血管内乳头状血管内皮瘤区域ERG阳性

图2B:海绵状血管瘤区域D2-40阴性

图2C:高分化血管肉瘤区域Ki-67阳性
最终诊断与讨论
最终病理诊断:
复合性血管内皮瘤(CHE),低度恶性。 建议结合临床密切随访。
讨论:
复合性血管内皮瘤 (CHE) 是一种罕见的血管源性肿瘤,具有局部侵袭性,但转移潜力较低。其核心特征是由比例不等的良性、中间性和恶性血管瘤成分混合构成,诊断需至少包含两种不同类型的血管肿瘤成分。由于其罕见性,关于CHE的大规模研究仍然有限。
临床特征: CHE可发生于各年龄段,但以成人多见,女性稍多。好发部位为四肢远端的浅表软组织(尤其是手足),少数可发生于头颈部(如本例的颌下腺)、躯干、肺、纵隔等。临床上常表现为与周围组织界限不清的团块状肿物,生长缓慢,呈浸润性。
镜下特征回顾: CHE的组织学形态多样,混合了不同级别的血管成分。良性成分可包括海绵状血管瘤、梭形细胞血管瘤等;中间型成分常见网状血管内皮瘤、血管内乳头状血管内皮瘤等;恶性成分则多为上皮样血管内皮瘤和血管肉瘤。本病例的成分组合较为典型,但以良性成分为主。
免疫组化特征: 肿瘤细胞通常表达血管内皮标记物(如ERG, FLI-1, CD31, CD34, F8)。值得注意的是,部分病例中CD34可能阴性或弱阳性,有时可表达淋巴管标记物Prox-1,提示可能存在向淋巴管分化的情况。
分子遗传学: 部分CHE病例,特别是伴有神经内分泌分化的亚型,可能检测到特定的基因融合,如 EPC1::PHC2 或 PT-BP1::MAML2。这些融合基因是否为CHE的特异性标志物仍需进一步研究。本病例未进行相关基因检测。
治疗与预后展望
CHE的主要治疗方法是局部广泛扩大切除。 对于区域淋巴结受累可疑或确定的患者,可能需要行淋巴结清扫。术后是否需要辅助放疗需根据病理结果综合判断。远处转移的患者则考虑化疗。
尽管CHE被归类为低度恶性肿瘤,其生物学行为通常比典型的血管肉瘤温和,远处转移罕见。然而,由于其浸润性生长和潜在的多中心性,局部复发的风险仍然存在,尤其是在切除不彻底的情况下。因此,精确诊断和合理的治疗策略至关重要,术后密切随访必不可少。 对于这类罕见肿瘤,获取全面准确的疾病信息和诊疗进展对患者和医生都非常有价值。
本例患者术后进行了电话随访(每3个月一次),目前暂未发现复发或转移迹象。
鉴别诊断要点
由于CHE成分复杂,病理诊断时需注意以下几点:
- 充分取材: 避免因取材局限导致只观察到单一成分而误诊。
- 全面阅片: 仔细观察所有切片,识别并区分良性、中间性和恶性区域的组织结构和细胞形态。
- 与单一类型血管肿瘤鉴别:
- 网状血管内皮瘤/乳头状淋巴管内血管内皮瘤 (Dabska瘤): 这两者虽有重叠,但通常成分单一,缺乏CHE中混合的其他良恶性成分。
- 上皮样血管内皮瘤/高分化血管肉瘤: 这两者作为CHE的恶性成分出现,但单独发生时,通常缺乏CHE所特有的良性和中间性成分混合。血管肉瘤通常侵袭性更强,预后更差。
准确的病理诊断对于指导后续治疗和判断预后至关重要。
